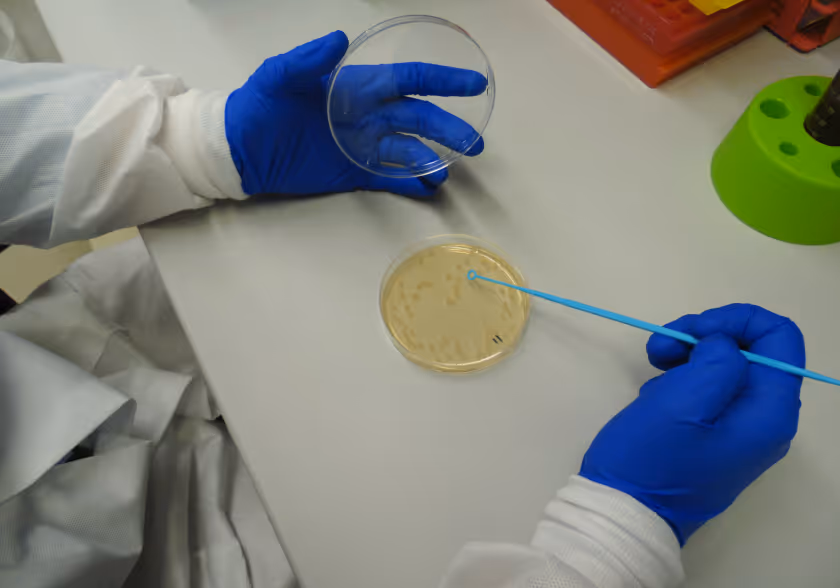

Resources
Explore our growing library of research, presentations, and technical materials. These resources showcase the collaborative work of our partners and the progress made across each stage of the translational pipeline.
Thank you! Your submission has been received!
Oops! Something went wrong while submitting the form.

Revolutionizing tuberculosis regimen development
Same class, different activity: Delamanid and pretomanid have comparable bactericidal activity but pretomanid potently inhibits Mycobacterium tuberculosis ribosomal rRNA synthesis

Phase 2C clinical trial of novel short-course regimens for the treatment of pulmonary tuberculosis: TBTC study 38/CRUSH-TB design

Deconvoluting drug interactions using M. tuberculosis physiologic processes: transcriptional disaggregation of the BPaL regimen in vivo

Translational Modeling of BTZ-043 to Predict Phase 2A Efficacy and Evaluate Drug-Drug Interactions With Bedaquiline, Pretomanid, and Linezolid in Murine Models

Contribution of front-line, standard-of-care drugs to bactericidal responses, resistance emergence, and cure in murine models of easy- or hard-to-treat tuberculosis disease

ACTG A5409 (RAD-TB): Study Protocol for a Phase 2 Randomized, Adaptive, Dose-Ranging, Open-Label Trial of Novel Regimens for the Treatment of Pulmonary Tuberculosis

Emergence of antibiotic-specific Mycobacterium tuberculosis phenotypes during prolonged treatment of mice
PReDiCTR Logo & Brand Assets
The logo depicts an interconnected network of nodes, symbolizing the systematic integration of heterogeneous data streams spanning preclinical models, biological assays, and translational evidence. This unified architecture reflects a data-driven framework designed to enable predictive insight into future clinical trial outcomes.
Download official PReDiCTR logos in multiple formats and sizes for use in presentations, publications, and partner materials.
Download Logos


.avif)
.avif)
.avif)